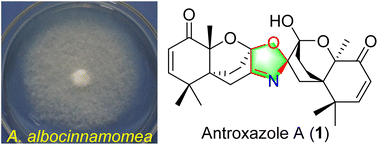
Graphical abstract: Antroxazole A, an oxazole-containing chamigrane dimer from the fungus Antrodiella albocinnamomea with immunosuppressive activity

Antroxazole A, an oxazole-containing chamigrane dimer from the fungus Antrodiella albocinnamomea with immunosuppressive activity†
Abstract
Antroxazole A (1), a chamigrane type sesquiterpene dimer containing an oxazole moiety, has been characterized from cultures of the fungus Antrodiella albocinnamomea. The structure with absolute configuration was determined by extensive spectroscopic methods and single crystal X-ray diffraction. A plausible biosynthetic pathway for 1 was proposed. Compound 1 exhibits inhibition specifically against the LPS-induced proliferation of B lymphocyte cells with an IC50 value of 16.3 μM.

Please wait while we load your content...
Please wait while we load your content...